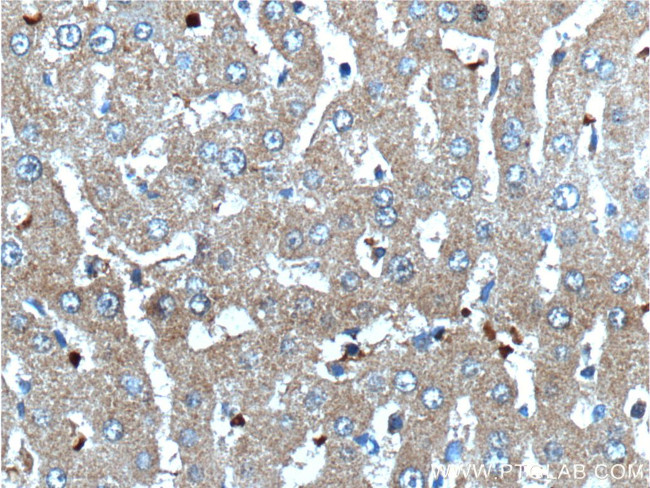
Angiogenin Antibody in Immunohistochemistry (Paraffin) (IHC (P))

Search
Proteintech
Angiogenin Polyclonal Antibody
{{$productOrderCtrl.translations['antibody.pdp.commerceCard.promotion.promotions']}}
{{$productOrderCtrl.translations['antibody.pdp.commerceCard.promotion.viewpromo']}}
{{$productOrderCtrl.translations['antibody.pdp.commerceCard.promotion.promocode']}}: {{promo.promoCode}} {{promo.promoTitle}} {{promo.promoDescription}}. {{$productOrderCtrl.translations['antibody.pdp.commerceCard.promotion.learnmore']}}
产品信息
18302-1-AP
种属反应
已发表种属
宿主/亚型
分类
类型
抗原
偶联物
形式
浓度
规格
纯化类型
保存液
内含物
保存条件
运输条件
靶标信息
Angiogenin (ANG or ANG I) is important for the process of neovascularization and formation of new blood vessels. ANG is similar to pancreatic ribonuclease A and functions as a tRNA-specific ribonuclease that abolishes protein synthesis by specifically hydrolyzing cellular tRNAs. It interacts with endothelial cell-surface actin and may cause changes in the cell cytoskeleton. ANG is thought to be involved in the development of solid tumors and its antagonists are capable of inhibiting tumor growth. Defects in ANG are the cause of susceptibility to amyotrophic lateral sclerosis type 9 (ALS9). Angiogenin is a genetic link between ALS and PD.
仅用于科研。不用于诊断过程。未经明确授权不得转售。
生物信息学
蛋白别名: Angiogenin; angiogenin, ribonuclease, RNase A family, 5; epididymis luminal protein 168; Homo sapiens epididymis luminal protein 168; MGC22466; MGC71966; Ribonuclease 5; ribonuclease A A1; ribonuclease A family member 5; RNase 5; RNASE4; unnamed protein product
基因别名: ALS9; ANG; HEL168; RAA1; RNASE4; RNASE5
UniProt ID: (Human) P03950
Entrez Gene ID: (Human) 283